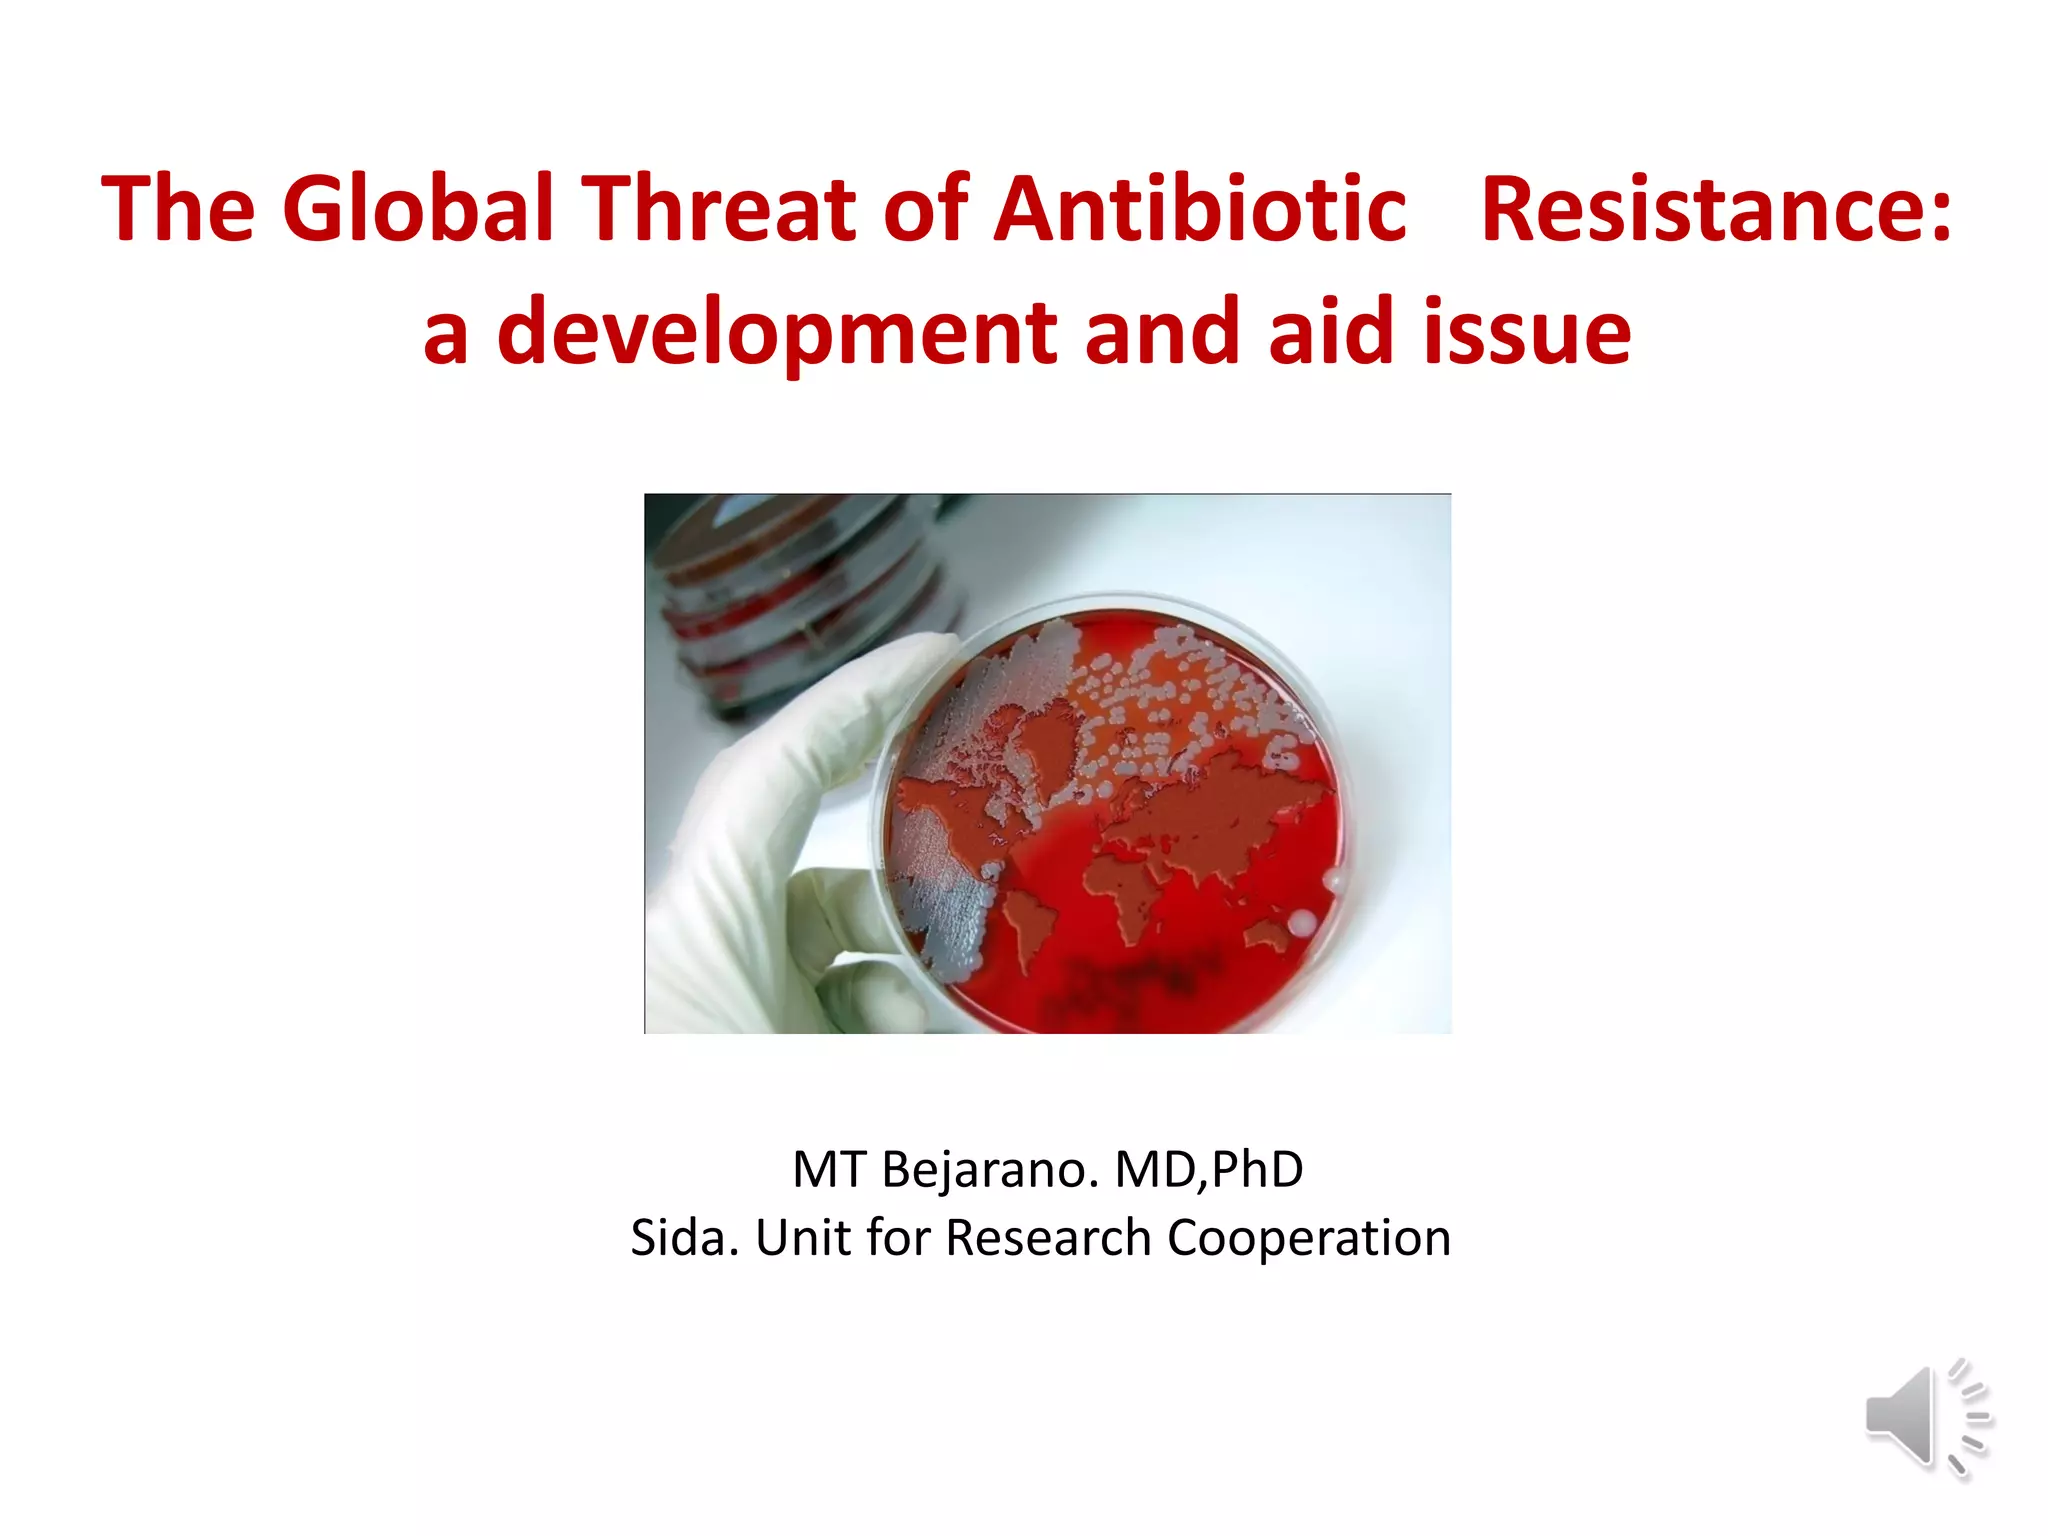

1) The document discusses the global threat of antibiotic resistance, noting it is a development and aid issue.
2) Key factors that have contributed to the rise of antibiotic resistance include overuse of antibiotics in agriculture, overprescription by doctors, lack of access to diagnostics in developing countries, and global travel and trade.
3) Addressing antibiotic resistance requires strengthening surveillance, rationalizing antibiotic use, securing access to effective antibiotics globally, developing new diagnostics and treatment guidelines, and reframing antibiotic resistance as a global health and development priority.